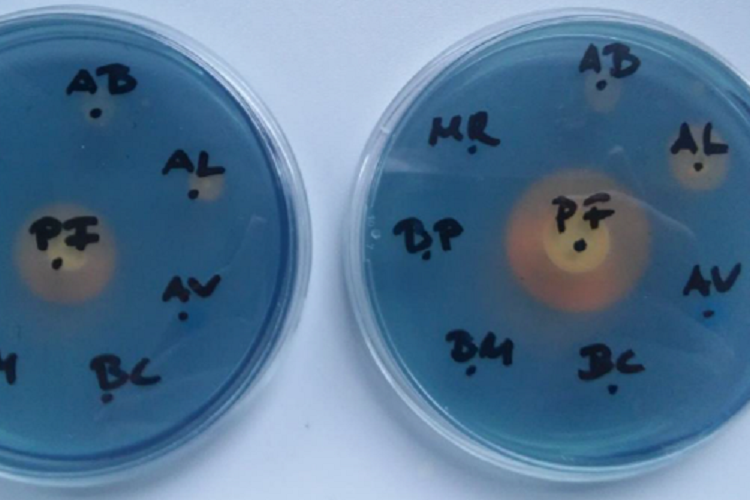
AGRO.bio AGRO.bio
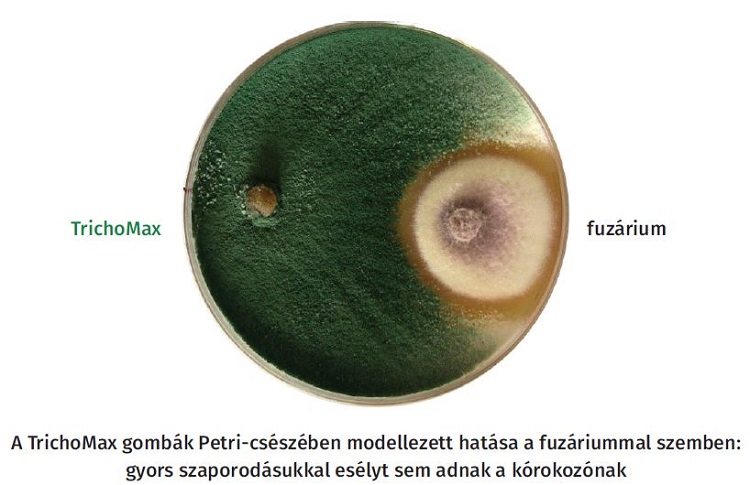
AGRO.bio AGRO.bio

A mikrobiológiai készítmények élő gombákat vagy baktériumokat, illetve zöldalgákat tartalmaznak, amelyek jótékony hatással vannak a talajegészségre és termesztett növényeinkre. Feltárják a tápanyagokat, elősegítik a kultúrnövény fejlődését és ellenállóvá teszik a stresszhatásokkal szemben. Cikkünkben bemutatjuk, hogy az AGRO.bio termékei milyen szerepet játszanak a bőven termő és egészséges, toxinmentes kukorica előállításában.
Fuzárium, a rettegett ellenség
A fuzárium toxintermelő penészgomba, amely főként a gabonaféléket betegíti meg. Hazánkban a legelterjedtebb fajai a Fusarium graminearum és a Fusarium culmorum. A növények a virágzás ideje alatt a legfogékonyabbak a fertőzésre, a meleg, a csapadék és a magas páratartalom elősegíti a gomba szaporodását. Folyamatos esőzések következtében az érett szemeken is kialakulhat a fuzáriumfertőzés és megindulhat a toxinképződés.
A fuzáriumtoxinok az állati és az emberi szervezetre egyaránt veszélyt jelentenek. Az Európában legelterjedtebb fuzárium a deoxinivalenol (DON) toxint termeli. A DON mellett veszélyesek lehetnek a fumonizinek is, amelyek a kukoricaőrleményekben találhatók.
Fuzáriumfertőzés tünete kukoricán – Fotó: AGRO.bio
Aszpergillusz: régi-új ellenség a kukoricában
A hazai kukoricatermesztők életét sokszor az aszpergillusz keseríti meg, a betakarított kukoricát ugyanis a gomba okozta aflatoxin-szennyezettség miatt nem veszik át a feldolgozóüzemek. A hazai aszpergillusz fertőzöttséget kukoricában elsősorban az Aspergillus flavus, Aspergillus parasiticus és Aspergillus niger fajok okozzák, amelyek szintén toxint termelnek.
Az aszpergilluszok meleg égövi kórokozók; hazánkban az utóbbi évek száraz és extrém magas hőmérsékleti viszonyai kedveztek a megjelenésüknek. Az optimális hőmérséklet a növekedésükhöz általában 20-30 °C között van. A betegség tünetei a csövön látható zöldessárga (Aspergillus flavus) vagy fekete (Aspergillus niger) konídium- (ivartalan spóra) gyep formájában jelennek meg.
A fertőzés kialakulását elősegítő tényezők a meleg, száraz időjárás, főleg betakarítás előtt, a növény legyengült egészségi állapota és a betegségekkel és a kártevőkkel szembeni védelem hiánya. A talajművelés (vetésforgó, talaj-előkészítés, a betakarítás utáni tárolás módja) szintén hatással van a fertőzöttség mértékére és közvetetten a mikotoxin-szennyezettségre is.
A magas páratartalom segíti a spórák csírázását és a gombák növekedését. A fertőzés emiatt a tárolóban is terjedhet és akár mikotoxin is termelődhet, ám a kórokozót a szántóföldről hurcoljuk be a tárolóba, ezért a szántóföldön érdemes felvenni ellene a harcot.
Lehetséges védekezési módok
Az aszpergilluszfertőzöttséget kukoricában leginkább megelőzni lehet, mivel rezisztens fajták nem állnak rendelkezésre. A legjobb lehetőségek az agrotechnikában rejlenek: vetésváltás, talajművelés és folyamatos monitoring. Ezen túl a rovarkártevők elleni megfelelő védekezés, az egészséges növényállomány, a megfelelő tárolási körülmények és a tárolás során is rendszeres monitoring segíthetnek csökkenteni a mikotoxin-szennyezettség kialakulásának kockázatát.
A fuzárium és az aszpergillusz elleni védekezésre nincs egyetlen csodamódszer. Kizárólag a Helyes Gazdálkodási Gyakorlat alkalmazása jelenthet megoldást, valamint növelni kell a növények ellenálló képességét a gombák ellen.
BactoFil® CELL, a szárbontás készítménye
A megelőzéshez a vas-kelát-képződésjelentős elősegítésére van szükség a talajban. A folyamatot a Pseudomonas fluorescens talajbaktériummal tudjuk előidézni, melyet az egyébként szárbontásra ajánlott BactoFil® CELL termékben találunk a legnagyobb arányban. Ezzel a fuzárium gomba szaporodását gátoljuk.
A vas-kelát-képző talajbaktérium-törzsek jelentősen csökkentik a talajban lévő kórokozók számát és a fertőzésük mértékét. A talajbaktériumok olyan anyagokat termelnek, amelyek gátolják a kórokozók szaporodását, szignifikánsan csökkentve a talajból eredő fertőzési nyomást.
A vas-kelát-képző baktériumok a kórokozók szaporodásához kedvezőtlen környezetet teremtenek. A képen a Pseudomonas fluorescens (PF-fel jelölve) törzsek körül jól láthatóak a feltisztulási zónák – Fotó: AGRO.bio
Mivel a kórokozó elhalt növényi maradványokon telel át, ezeket nem célszerű a talajfelszínen hagyni, továbbá ajánlatos BactoFil® CELL-lel segíteni a növényi maradványok mielőbbi elbontását a talajban.
A szárbontásra kifejlesztett, 2008 óta elérhető és bizonyítottan kiválóan működő BactoFil® CELL egyedülálló mikrobiológiai gyökér- és szármaradványbontó készítmény jelentősen meggyorsítja a szár- és gyökérmaradványok elbomlását. Mikroorganizmusai – közte a Cellvibrio ostraviensis baktériumok – elbontják a növénymaradványok cellulóz- és hemicellulózrostjait, így a bennük lévő tápanyagok jelentős része a következő kultúra számára felvehetővé válik, továbbá megkötik a légköri nitrogént is a pentozánhatás elkerülésére.
Így a BactoFil® CELL alkalmazásakor nem kell nitrogénműtrágyát adagolni a szárbontáshoz (műtrágya-megtakarítás). A készítmény csökkenti a növénymaradványokból a talajba került kórokozók életterét, visszaszorítja a szaporodásukat, ezáltal a következő kultúráknak kisebb fertőzési nyomással kell megküzdeniük (hatékonyabb növényvédelem). Az elbomlott rostok megkönnyítik a talajművelést, hiszen a talajközeli szármaradvány morzsalékos állagúra bomlik, a talajmunkák üzemanyagköltsége lényegesen csökken.
A nitrátérzékeny területeken korlátlanul használható BactoFil® CELL az év egyik felében melegtűrő, míg a másik felében hidegtűrő baktériumtörzs-változatokat tartalmaz, a minél rugalmasabb és hatékonyabb felhasználás érdekében, amit villámgyors kiszállítással is támogatunk.
A Trichoderma gombák összetett hatása a kórokozók ellen
A Trichoderma gombát tartalmazó termékek között találunk növényvédő szert, valamint termésfokozó készítményt is, bár a két termékkör hatásmódja azonos. Eltérések csak az egyes Trichoderma törzsek hatékonyságában lehetnek.
Fotó: AGRO.bio
TrichoMax
Az egyik legerősebb biokontrollhatással rendelkező Trichoderma a TrichoMax®-ban lévő Trichoderma harzianum.
A TrichoMax megváltoztatja a mikroflorális összetételt a növények gyökérzete körül, amiből számos előny adódik: kapcsolat alakul ki a Trichoderma harzianum és a kultúrnövény között, ami serkenti a gyökérfejlődést; javul a tápanyagok felvétele; és szerzett rezisztenciát indukál, javítva a növények természetes védekezési mechanizmusát. A gomba kontrollálja a talajból támadó gombákat (biokontrollhatás): elvonja a patogén gombák elől a tápanyagokat; direkt módon parazitálja a talajban fejlődő növénykárosító gombákat (lebontja azok szaporodóképleteit); és robbanásszerű fejlődésének köszönhetően nem hagy teret a fitopatogén gombák fejlődésének.
Különösen silókukorica esetében érdemes a BactoFil® Kukorica és az Algafix hatását a TrichoMax termékkel tovább erősíteni,amely minimálisra csökkenti a toxintermelő gombák fertőzési nyomását.
A nyereséges kukoricatermesztés kulcsa a mikrobiológiai támogatás
Nem minden mikrobiológiai készítmény szolgál a károsítók elleni védekezésre: vannak olyanok, amelyek közvetlenül a nagyobb és jobb minőségű termés kialakulását segítik. A BactoFil® talajbaktérium-készítményektől akkor várhatjuk a legjobb hatást,ha növénykultúrától függően illesztjük be a tápanyag-utánpótlási és növényvédelmi technológiába.
BactoFil® Kukorica
A termékben 6 talajbaktérium-törzs található, a kukorica számára optimális arányban. Ezek egyrészt nitrogént kötnek meg, másrészt felvehető formába hozzák a talaj lekötődött foszfor- és káliumtartalmát. A BactoFil® Kukorica-kezelés hektáronként 60 kg N, valamint 35-35 kg/ha P és K hatóanyagot tartalmazó műtrágyahatásával egyenértékű éves szinten, ami gazdasági oldalról is komoly érv az alkalmazása mellett.
Egyes törzsek olyan növényi hormonokat termelnek (IES), amelyek hatására a kukorica nagyobb gyökértömeget fejleszt; ellenállóbb egyes kártevők gyökérkártétele esetén; több vizet és tápanyagot tud felvenni; erőteljesebben fejlődik; jobban tűri a szárazságot; és több termést ad.
A BactoFil® Kukoricát 1,0 liter/hektáradagban vetés előtt, magágykészítéskor kell a talajra permetezni és azonnal a talajba forgatni.
Algafix – verhetetlen a stresszkezelésben
A kukorica az intenzív lombfejlődés szakaszában számos stresszhatásnak van kitéve. Az Algafix olyan élő balatoni zöldalgát– és az általa termelt növényi hormonokat – tartalmaz, amely jelentősen javítja a növény stressztűrő képességét; fokozza a tápanyag- és vízfelvételt; gyorsítja a növény fejlődését; és serkenti a növekedést.
Ebben rejlik az Algafix utolérhetetlen növénytámogató hatása. Az Algafix adagja 1,0–2,0 liter hektáronként. Szántóföldi permetezővel önmagában vagy lombtrágyával együtt kijuttatva tökéletesen kiegészíti és fokozza a BactoFil® Kukorica hatását.
AlgaTer® – Európában is egyedülálló biológiai talajtakarás
Az AlgaTer® Klebsormidium bilatum fonalas zöldalgát tartalmazó talajoltó készítmény. A talaj felszínén képes szaporodni és fotoszintetizálni. Biofilmet képez a talajon – átszőve a felső 5-20 cm-t –, ami megakadályozza a csepperózió által okozott gombaspórás felfertőzést a talajfelszínről.
Az AlgaTer® az egyik legfontosabb eleme a mikrobiális megelőző technológiának, alkalmazása számos előnnyel jár:
- nagyobb, biztonságosabb hozam,
- erózió és defláció elleni védelem,
- aktív nedvességmegőrzés,
- magasabb szervesanyag-tartalom,
- javuló talajszerkezet.
A kukorica gombás fertőzései komoly fenyegetést jelentenek a termelésre, azonban az integrált védekezés – a megfelelő agrotechnikai módszerek és az AGRO.bio mikrobiológiai megoldásai– hosszú távú sikert biztosít. A BactoFil®CELL, TrichoMax, BactoFil® Kukorica, Algafix és AlgaTer® készítmények nemcsak a fertőzések megelőzésében és kezelésében eredményesek, hanem hozzájárulnak a fenntartható gazdálkodáshoz és a talaj egészségének megőrzéséhez is.
Keresse területi szaktanácsadó kollégáinkat, akik készséggel állnak rendelkezésre, akár szakmai segítségre, akár gyors szállításra van szüksége, vagy az aktuális akcióink iránt érdeklődik.
Daoda Zoltán – Kabai Gábor
AGRO.bio Hungary Kft.
www.agrobio.hu

_fill_540x300_0.jpg)
_fill_540x300_0.jpg)
_fill_540x300_0.jpg)
_fill_540x300_0.jpg)



_fill_540x300_0.jpg)

